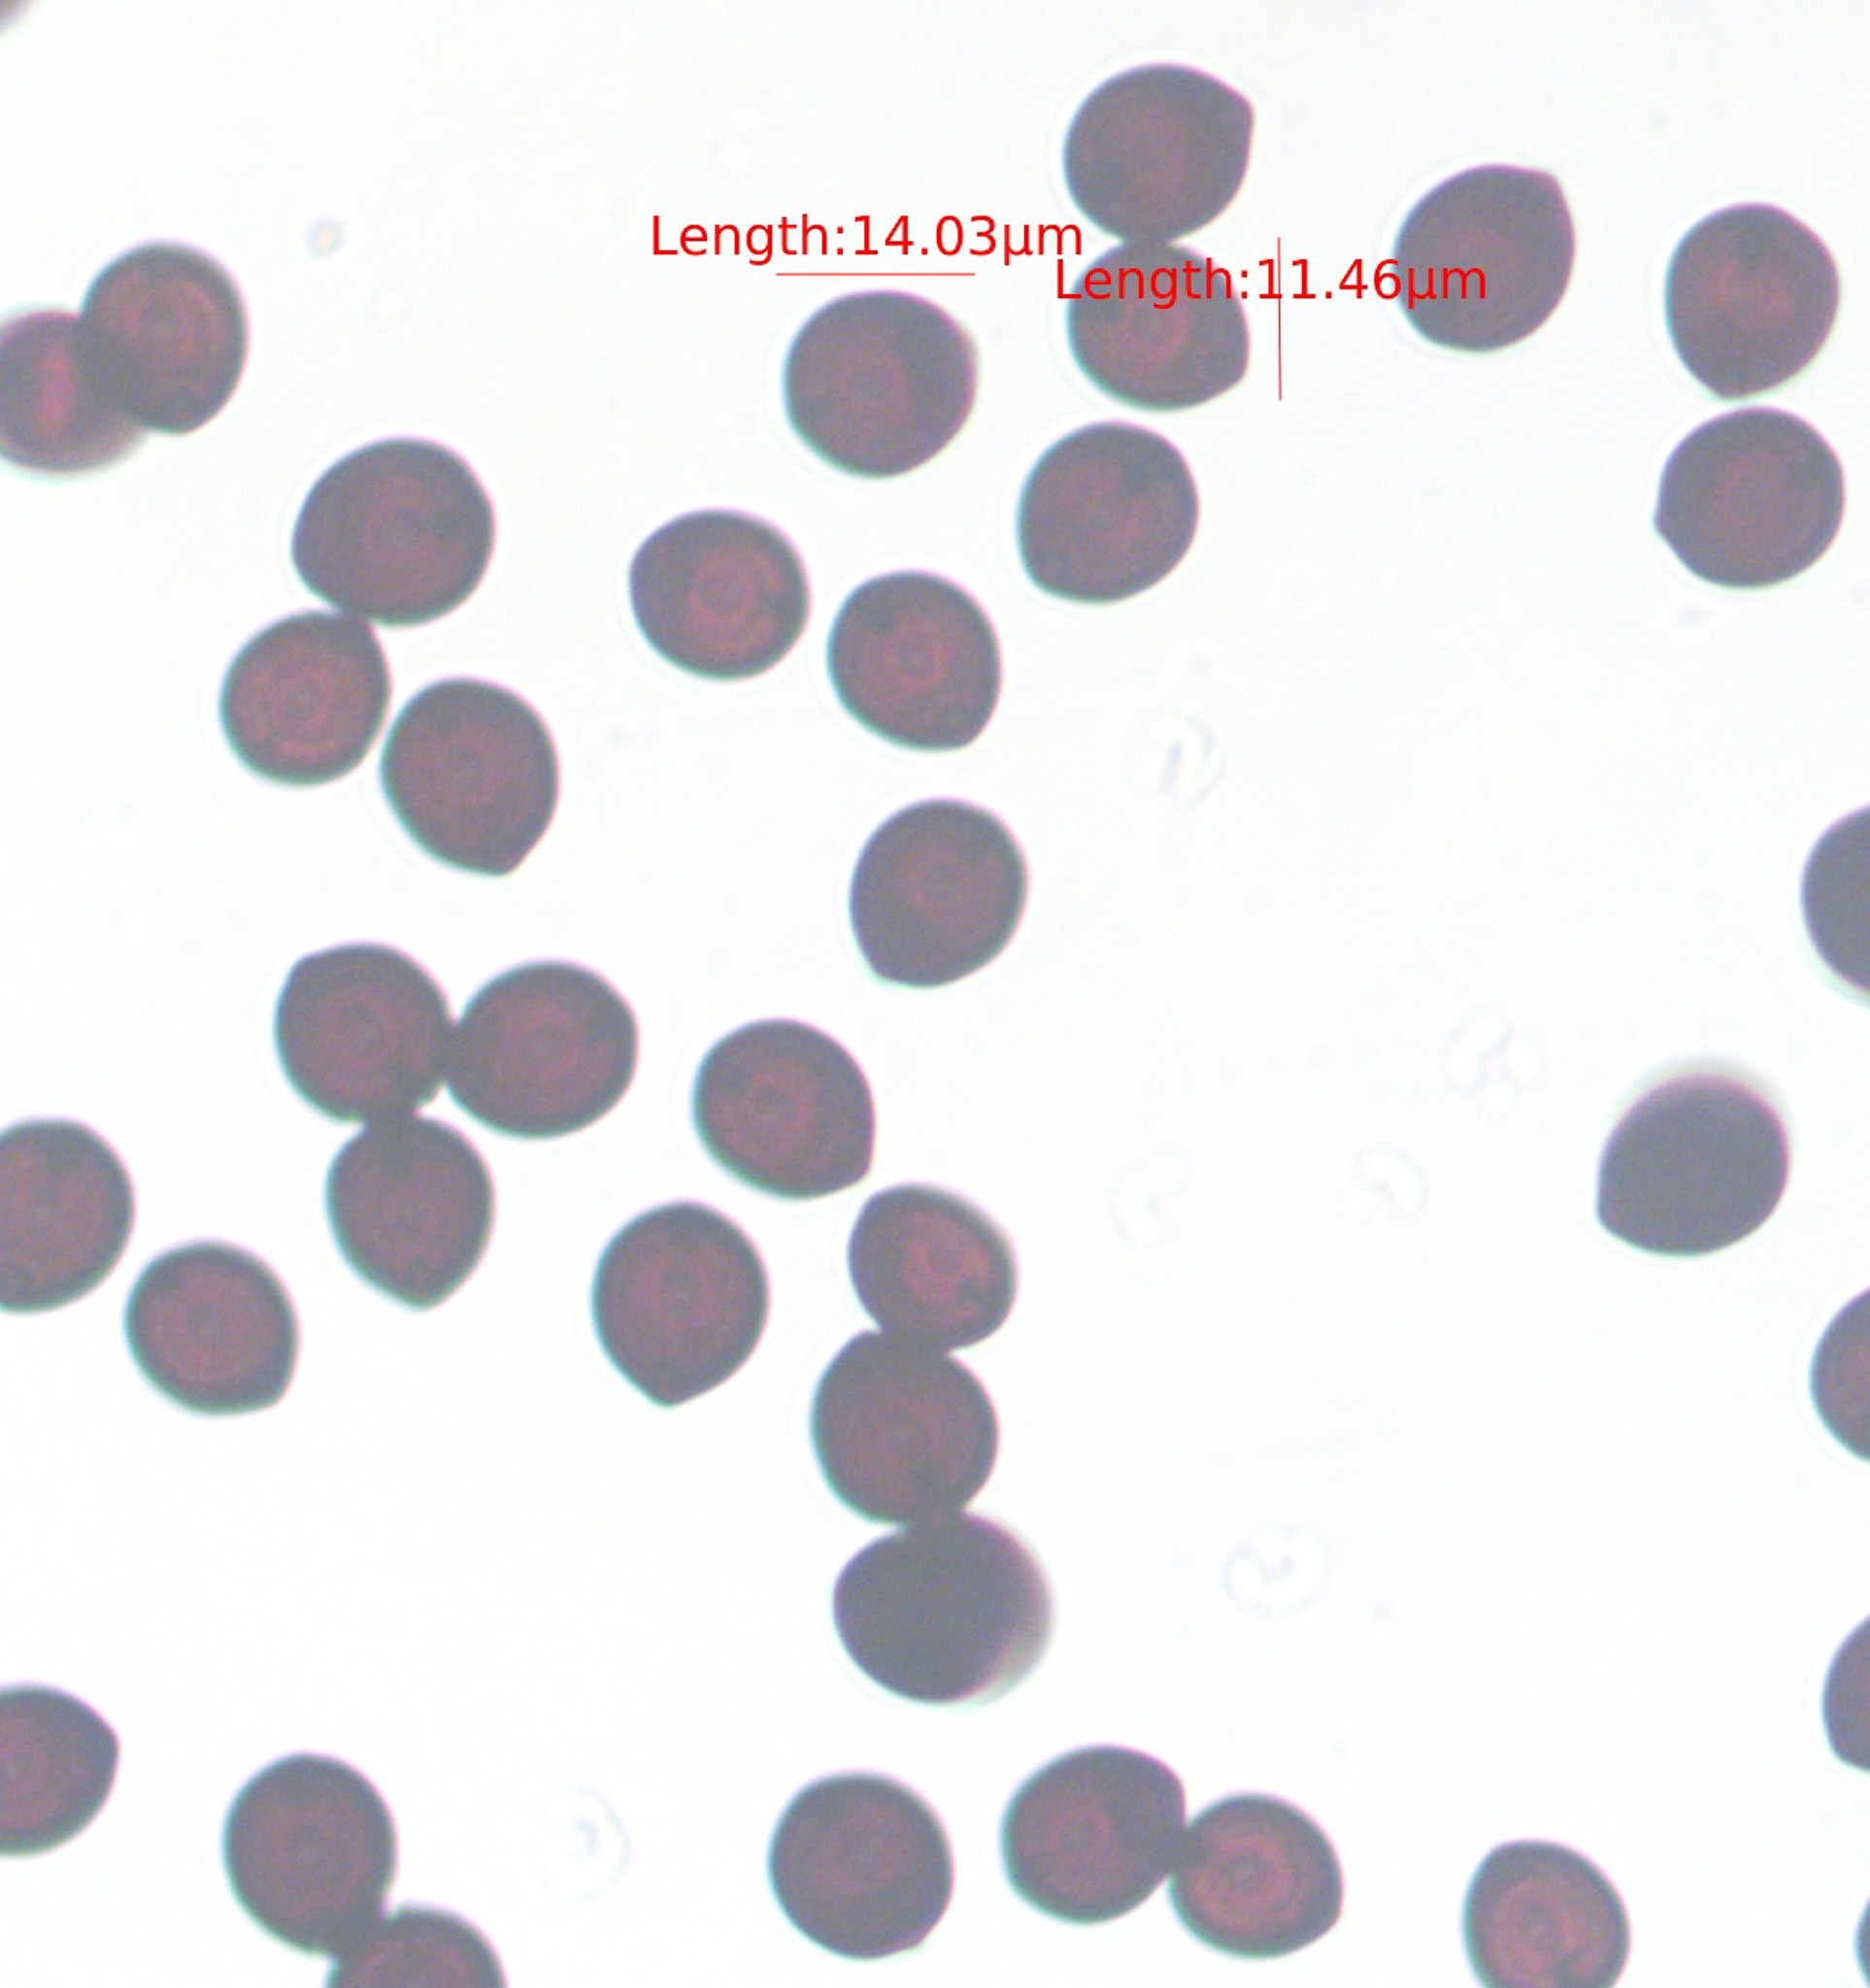
WRJ 0061

Mushroom Name: WRJ 0061
Image Information (EXIF Data)
Dimensions
1926x2048
Mushroom Part
Not specified
Camera Make
N/A
Camera Model
N/A
Lens
N/A
Exposure
N/A
Aperture
N/A
ISO
N/A
File Size
539 KB
File Type
image/jpeg
Uploaded
November 20, 2025 at 07:08 AM
Last Updated
November 20, 2025 at 07:08 AM